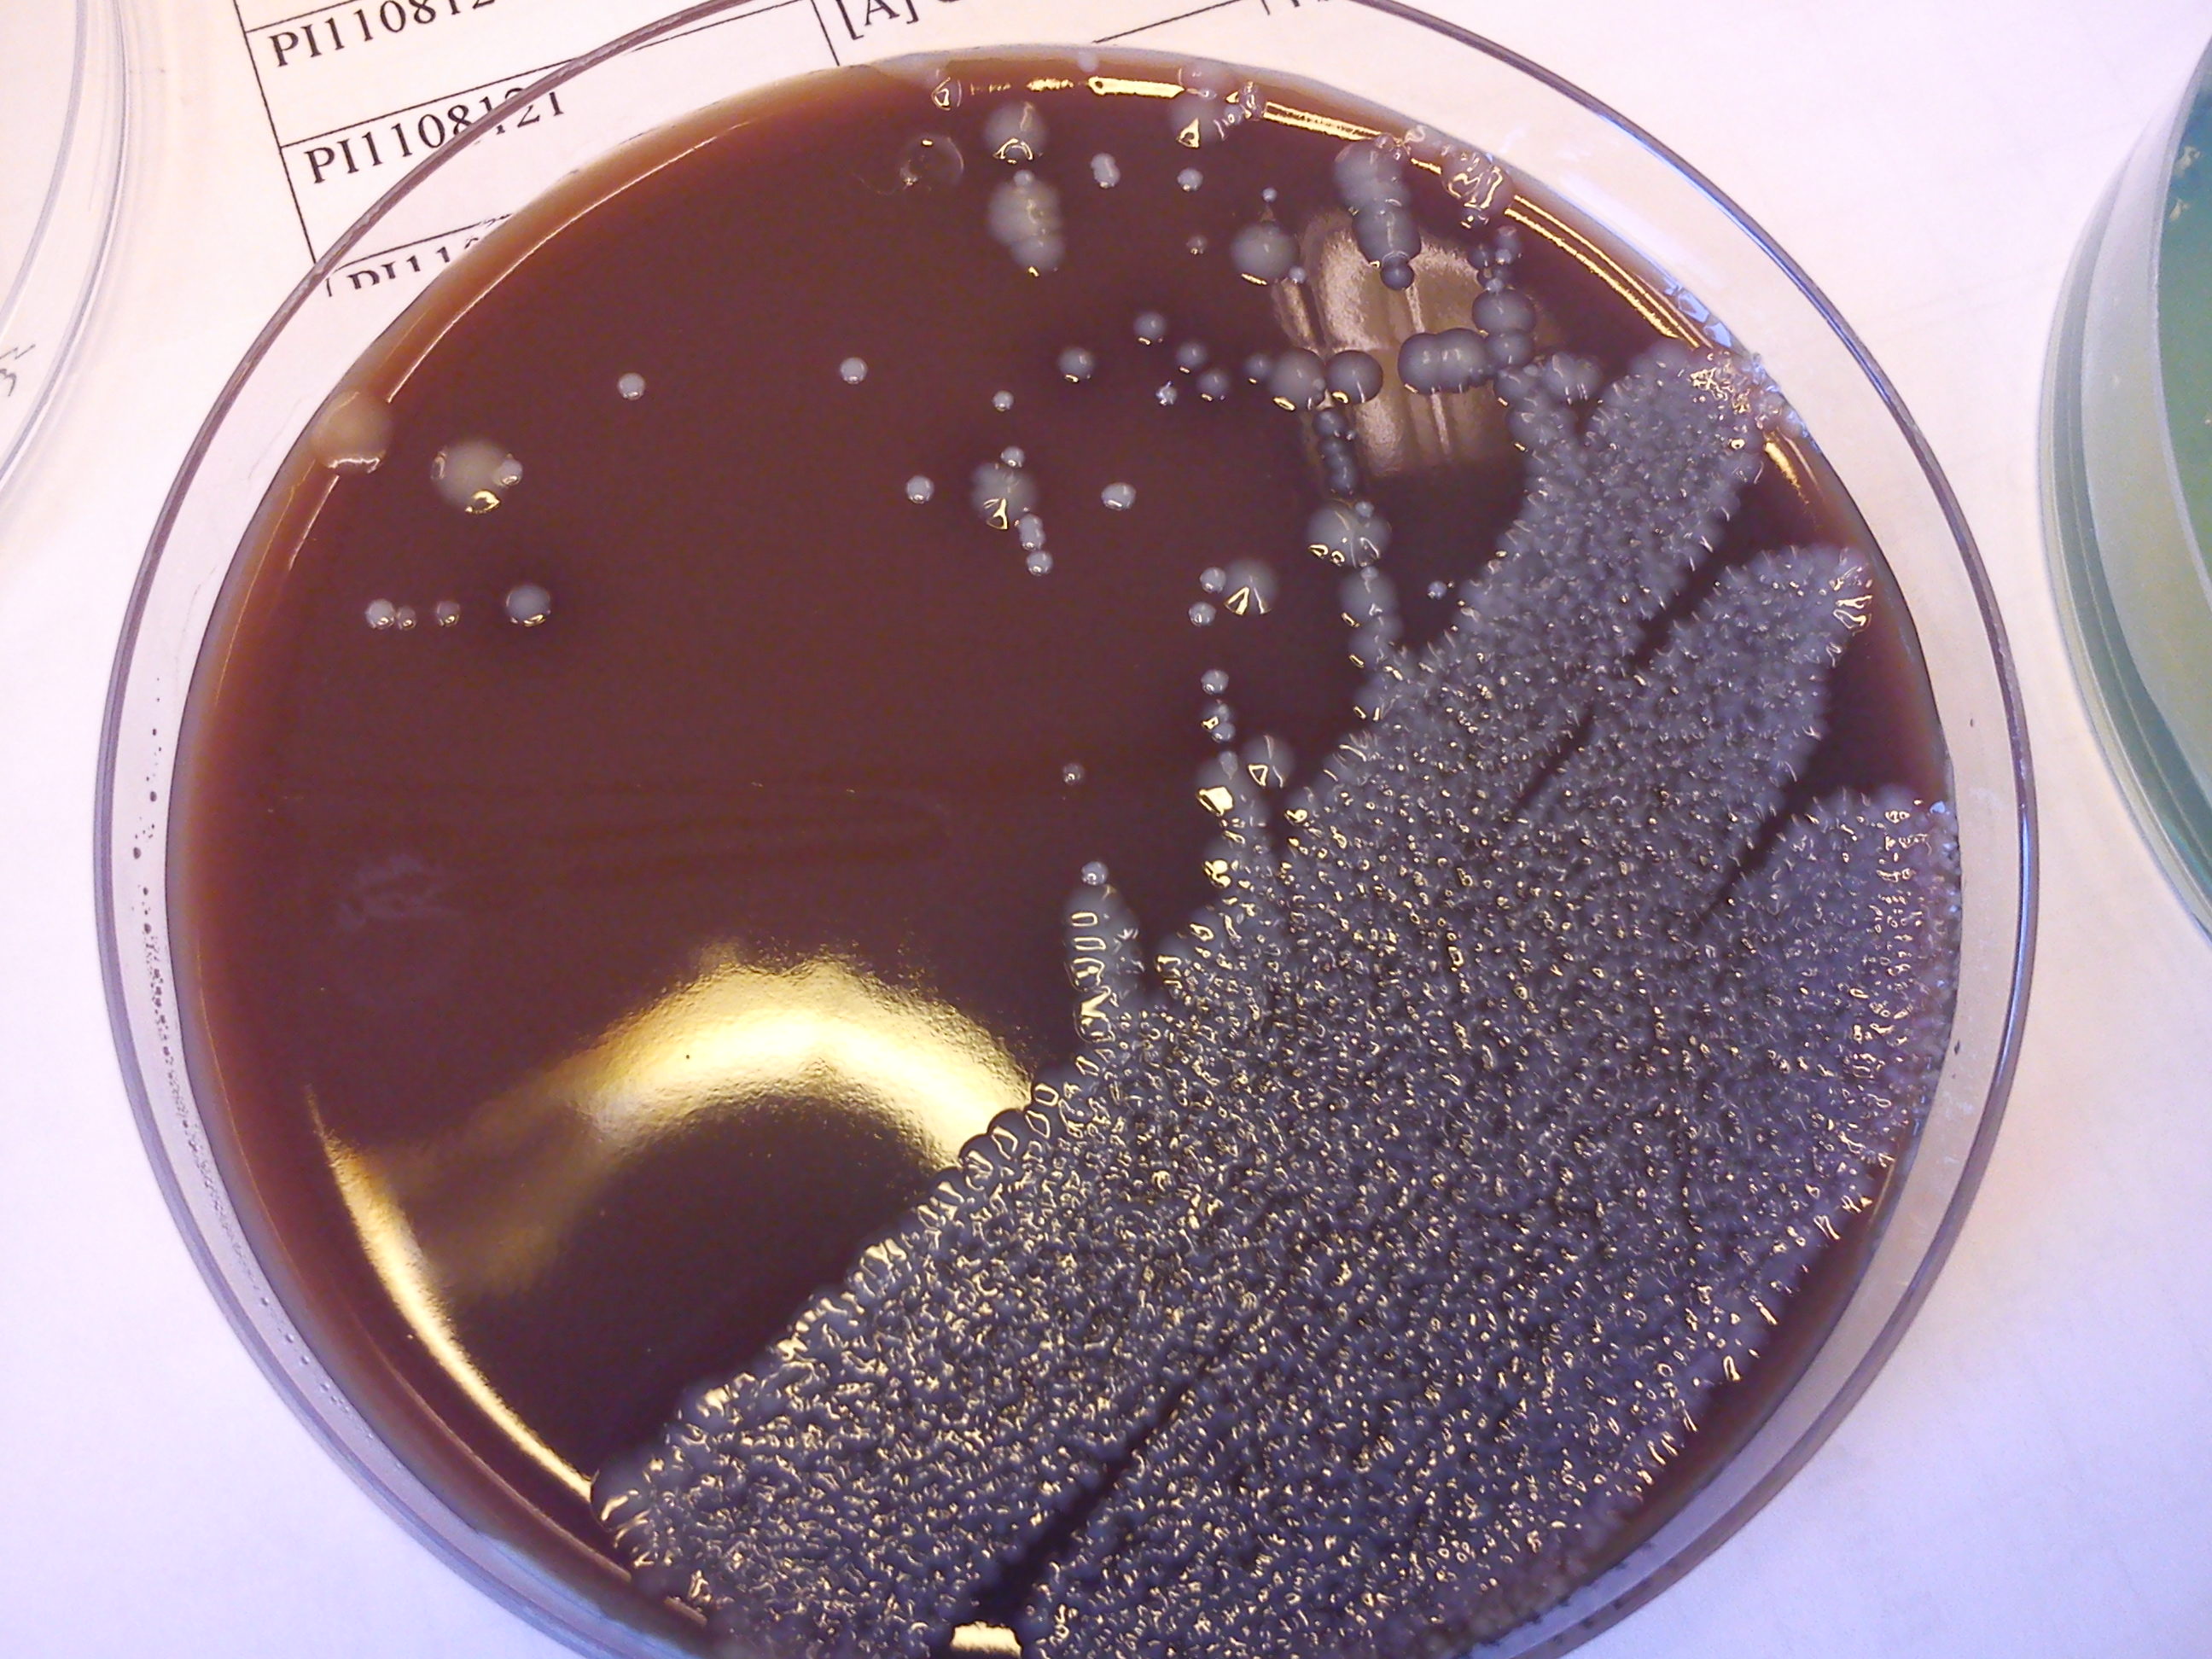

När man är på fest och står där på dansgolvet kan man lätt känna sig som tjugo igen. Ung och hipp som som sällan förr! Hur ska man yr av festglädje veta om man blott är 20 tjugo vårar eller om man har börjat gå mot höst?
Här är några tecken på att du kan ha passerat de fagra ungdomsåren:
Om du innan förfesten:
- istället för att välja några söta underkläder får ta ett par rejäla med gördel som håller in magen. Och när du ser att magen istället hänger ut ovanför gördeln så tycker du inte att det gör något.
På väg till förfesten:
- istället för att sitta i baksätet och skvimpa grogg och kolla i spegeln så sitter du och petar tänderna. Helt ogenerat dessutom.
På förfesten:
- istället för att bara prata med närmsta kompisen och stärka dig med dryckesjom innan förfesten har kommit igång på riktigt så pratar du vitt och brett med alla om dig själv (samtidigt som du drar i gördeln).
På festen:
- envisas med att skämta med alla om din ålder (får jag verkligen vara uppe så här sent?) samtidigt som du tycker att alla som är några år yngre än du ”bara är barnet”.
- blir så till dig när bandet lovar att de ska spela Michelangelo att du utstöter ett litet ”Iiiihhh” och hoppar av glädje. Tror du. Egentligen brölar du ett ”Ööööhh” och råkar lägga en liten rap.
På väg hem:
- istället för att le för att du är lullig och har känt dig omsvärvad så går du med ett fånleende för att du vet att det ligger kyckling hemma i kylen som du kan äta när du kommer hem.
OBS! Om du när festen är slut kommer på att du har stått på samma ställe och pratat om samma sak hela kvällen så är du inte bara gammal. Då är du dessutom en man.